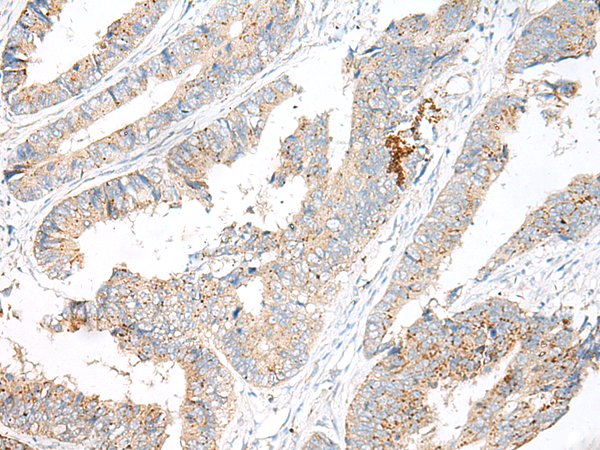

中文名稱: 兔抗GARNL3多克隆抗體
相關類別: 一抗
|
Background: |
The function of this protein remains unknown. |
|
Applications: |
ELISA, IHC |
|
Name of antibody: |
GARNL3 |
|
Immunogen: |
Synthetic peptide of human GARNL3 |
|
Full name: |
GTPase activating Rap/RanGAP domain like 3 |
|
Synonyms: |
bA356B19.1 |
|
SwissProt: |
Q5VVW2 |
|
ELISA Recommended dilution: |
5000-10000 |
|
IHC positive control: |
Human colorectal cancer and Human thyroid cancer |
|
IHC Recommend dilution: |
40-200 |

購物車
購物車 幫助
幫助
 021-54845833/15800441009
021-54845833/15800441009
